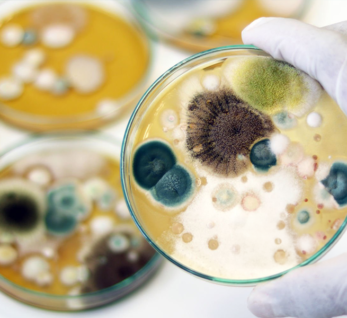

- Naxçıvan ş. C.Məmmədquluzadə küç. 24
Lorem ipsum dolor sit amet, consectet eiusmod tempor incididunt ut labore e rem ipsum dolor sit amet. sum dolor sit amet, consectet eiusmod.
Visiting Hours
| Mon - Fri: | 8:00 am - 8:00 pm |
| Saturday: | 9:00 am - 6:00 pm |
| Sunday: | 9:00 am - 6:00 pm |
Gallery Posts